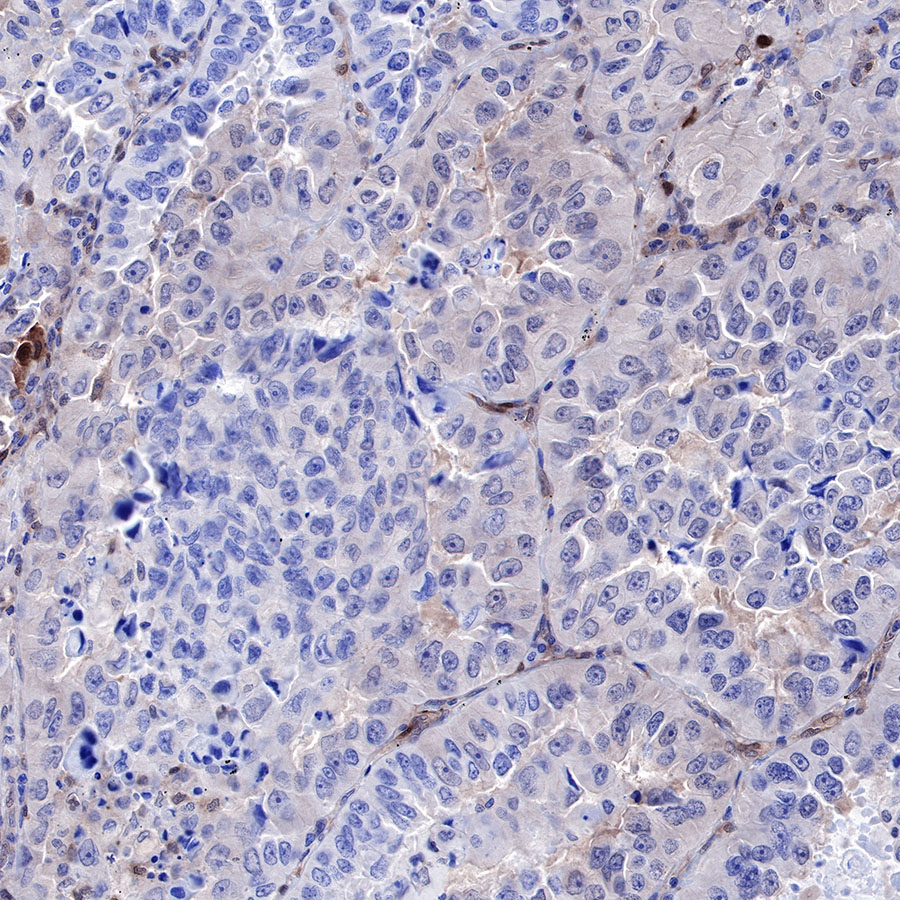
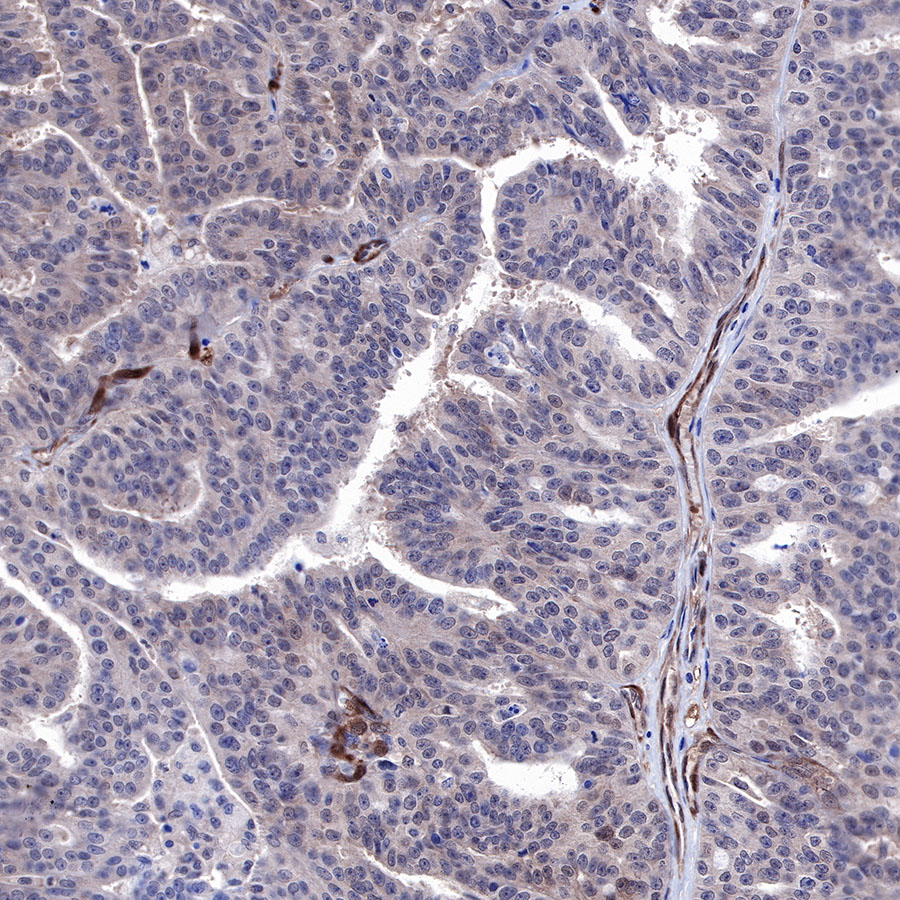

WB result of PTEN Rabbit mAb
Primary antibody: PTEN Rabbit mAb at 1/1000 dilution
Lane 1: MCF7 whole cell lysate 20 µg
Secondary antibody: Goat Anti-Rabbit IgG, (H+L), HRP conjugated at 1/10000 dilution
Predicted MW: 47 kDa
Observed MW: 54 kDa
Exposure time: 180s
Product Details
Product Details
Product Specification
| Host | Rabbit |
| Antigen | PTEN |
| Synonyms | MMAC1, TEP1 |
| Immunogen | N/A |
| Location | Cytoplasm, Nucleus |
| Accession | P60484 |
| Clone Number | SDT-R074 |
| Antibody Type | Rabbit mAb |
| Application | WB, IHC-P, ICC, ICFCM |
| Reactivity | Hu, Ms, Rt |
| Purification | Protein A |
| Concentration | 0.5 mg/ml |
| Physical Appearance | Liquid |
| Storage Buffer | PBS, 40% Glycerol, 0.05%BSA, 0.03% Proclin 300 |
| Stability & Storage | 12 months from date of receipt / reconstitution, -20 °C as supplied |
Dilution
| application | dilution | species |
| IHC-P | 1:500-1:1000 | null |
| WB | 1:1000 | null |
| ICFCM | 1:500 | null |
| ICC | 1:500 | null |
Background
PTEN is a dual-specificity phosphatase at two levels. First, PTEN has been shown to dephosphorylate protein substrates on serine/threonine and tyrosine residues, thus acting as a dual-specificity protein phosphatase. One example is the tyrosine dephosphorylation of focal adhesion kinase (FAK) to inhibit cell spreading. Second, PTEN also dephosphorylates phosphatidylinositol 3,4,5-trisphosphate (PIP3) to phosphatidylinositol 4,5-bisphosphate (PIP2) — hence, PTEN is also a dual-specificity phosphatase in the sense that it dephosphorylates lipid substrates in addition to protein substrates.
Picture
Picture
Western Blot


WB result of PTEN Rabbit mAb
Primary antibody: PTEN Rabbit mAb at 1/1000 dilution
Lane 1: C6 whole cell lysate 20 µg
Lane 2: PC-12 whole cell lysate 20 µg
Lane 3: rat brain lysate 20 µg
Secondary antibody: Goat Anti-Rabbit IgG, (H+L), HRP conjugated at 1/10000 dilution
Predicted MW: 47 kDa
Observed MW: 54 kDa
Exposure time: 180s

WB result of PTEN Rabbit mAb
Primary antibody: PTEN Rabbit mAb at 1/1000 dilution
Lane 1: mouse brain lysate 20 µg
Secondary antibody: Goat Anti-Rabbit IgG, (H+L), HRP conjugated at 1/10000 dilution
Predicted MW: 47 kDa
Observed MW: 54 kDa
Exposure time: 180s
FC

Flow cytometric analysis of A431 cells labelling PTEN antibody at 1/500 (0.1 μg) dilution/ (red) compared with a Rabbit monoclonal IgG (Black) isotype control and an unlabelled control (cells without incubation with primary antibody and secondary antibody) (Blue). Goat Anti-Rabbit IgG Alexa Fluor® 488 was used as the secondary antibody.
Immunohistochemistry

IHC shows positive staining in paraffin-embedded human cervical carcinoma. Anti-PTEN antibody was used at 1/500 dilution, followed by a HRP Polymer for Mouse & Rabbit IgG (ready to use). Counterstained with hematoxylin. Heat mediated antigen retrieval with Tris/EDTA buffer pH9.0 was performed before commencing with IHC staining protocol.

IHC shows positive staining in paraffin-embedded human colon cancer. Anti-PTEN antibody was used at 1/500 dilution, followed by a HRP Polymer for Mouse & Rabbit IgG (ready to use). Counterstained with hematoxylin. Heat mediated antigen retrieval with Tris/EDTA buffer pH9.0 was performed before commencing with IHC staining protocol.
IHC shows positive staining in paraffin-embedded human lung cancer. Anti-PTEN antibody was used at 1/500 dilution, followed by a HRP Polymer for Mouse & Rabbit IgG (ready to use). Counterstained with hematoxylin. Heat mediated antigen retrieval with Tris/EDTA buffer pH9.0 was performed before commencing with IHC staining protocol.
IHC shows positive staining in paraffin-embedded human ovarian carcinoma. Anti-PTEN antibody was used at 1/500 dilution, followed by a HRP Polymer for Mouse & Rabbit IgG (ready to use). Counterstained with hematoxylin. Heat mediated antigen retrieval with Tris/EDTA buffer pH9.0 was performed before commencing with IHC staining protocol.

IHC shows positive staining in paraffin-embedded human pancreas. Anti-PTEN antibody was used at 1/500 dilution, followed by a HRP Polymer for Mouse & Rabbit IgG (ready to use). Counterstained with hematoxylin. Heat mediated antigen retrieval with Tris/EDTA buffer pH9.0 was performed before commencing with IHC staining protocol.

IHC shows positive staining in paraffin-embedded mouse cerebral cortex. Anti-PTEN antibody was used at 1/1000 dilution, followed by a HRP Polymer for Mouse & Rabbit IgG (ready to use). Counterstained with hematoxylin. Heat mediated antigen retrieval with Tris/EDTA buffer pH9.0 was performed before commencing with IHC staining protocol.

IHC shows positive staining in paraffin-embedded rat cerebral cortex. Anti-PTEN antibody was used at 1/1000 dilution, followed by a HRP Polymer for Mouse & Rabbit IgG (ready to use). Counterstained with hematoxylin. Heat mediated antigen retrieval with Tris/EDTA buffer pH9.0 was performed before commencing with IHC staining protocol.
Immunocytochemistry

ICC shows positive staining in A431 cells. Anti-PTEN antibody was used at 1/500 dilution (Green) and incubated overnight at 4°C. Goat polyclonal Antibody to Rabbit IgG - H&L (Alexa Fluor® 488) was used as secondary antibody at 1/1000 dilution. The cells were fixed with 4% PFA and permeabilized with 0.1% PBS-Triton X-100. Nuclei were counterstained with DAPI (Blue).Counterstain with tubulin (Red).
























